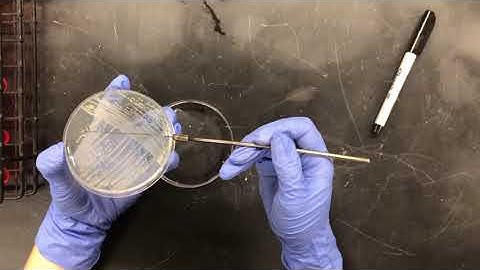
Exercise 7 - Fermentation of Carbohydrates

⬇ DOWNLOAD NOW
Kalau muncul iklan pop-up, tutup lalu klik tombol kembali
Download lagu Hybrid Micro Lab 7: Fermentation, Cellular Respiration, Reduction Potential secara gratis hanya untuk keperluan promosi. Dukung artis favorit kamu dengan membeli musik original di iTunes atau platform resmi lainnya.
 Micro Lab 7: Biochemical Differential Tests- Fermentation, Cellular Respiration, Reduction Potential
Micro Lab 7: Biochemical Differential Tests- Fermentation, Cellular Respiration, Reduction Potential
 ONLINE Micro Lab 7: Fermentation, Cellular Respiration, Reduction Potential
ONLINE Micro Lab 7: Fermentation, Cellular Respiration, Reduction Potential
 lab 7 micro
lab 7 micro
 Fermentation
Fermentation
 Yeast Cellular Respiration Lab
Yeast Cellular Respiration Lab
 Micro Lesson 7: Enzymes, Cellular Respiration and Fermentation
Micro Lesson 7: Enzymes, Cellular Respiration and Fermentation
Exercise 7 - Fermentation of Carbohydrates
Exercise 7 - Fermentation of Carbohydrates
 LSU Biol 2051 - Microbiology Lab - Fermentation
LSU Biol 2051 - Microbiology Lab - Fermentation